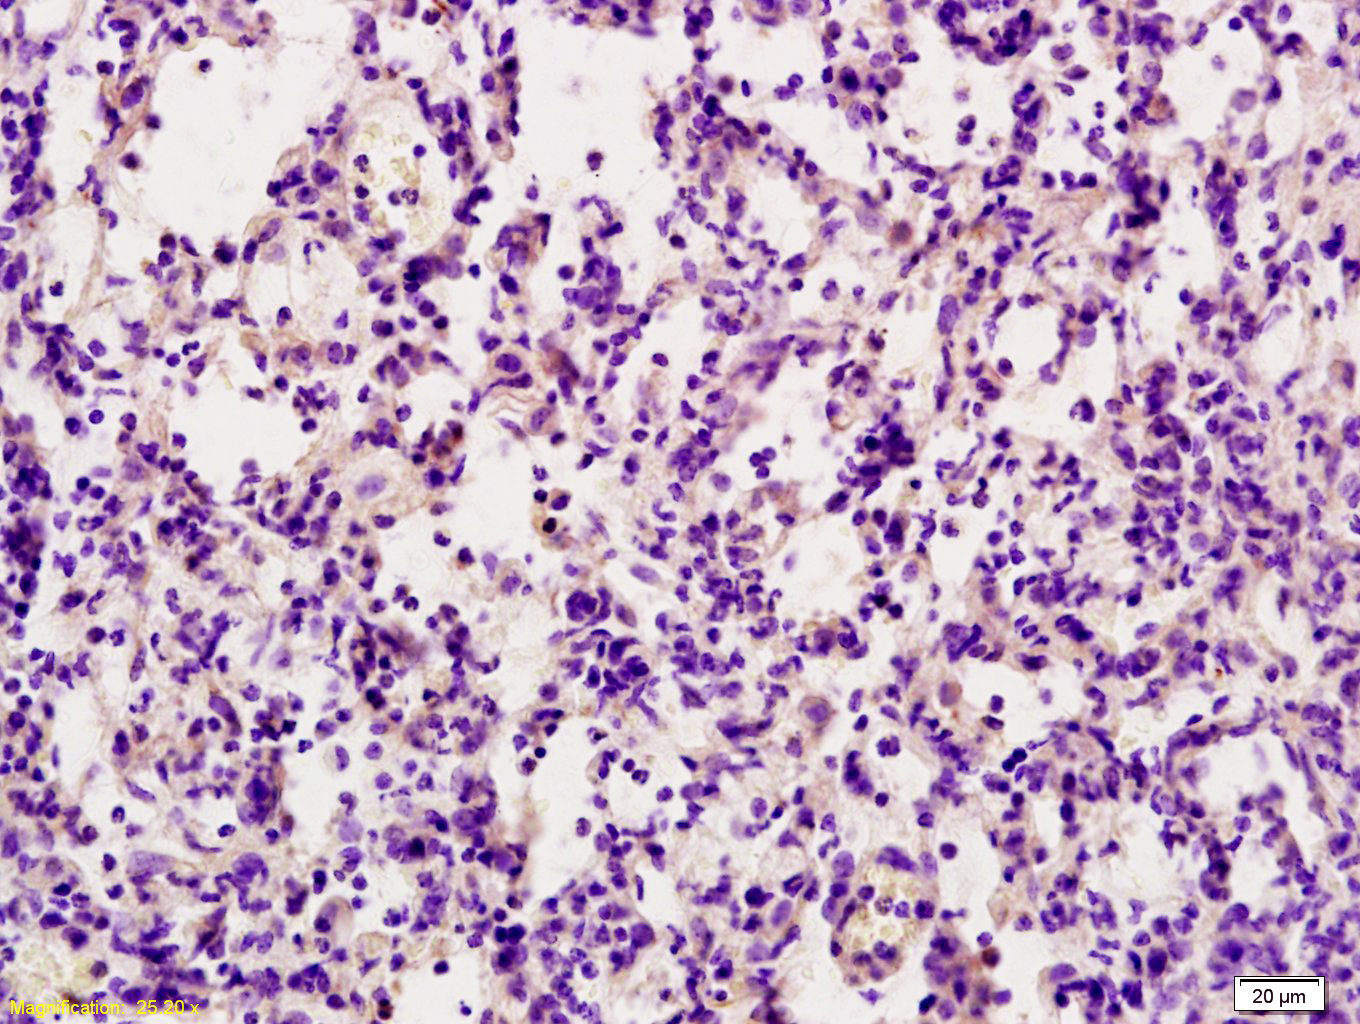
产品细节图片2

相关产品推荐更多 >
万千商家帮你免费找货
0 人在求购买到急需产品
- 详细信息
- 文献和实验
- 技术资料
- 应用范围:
产品信息以Bioss网站为准
- 规格:
50ul/100ul/200ul
| 规格: | 50ul | 产品价格: | ¥1180.0 |
|---|---|---|---|
| 规格: | 100ul | 产品价格: | ¥1980.0 |
| 规格: | 200ul | 产品价格: | ¥2800.0 |
| 产品编号 | bs-1214R |
| 英文名称 | TRAIL Rabbit pAb |
| 中文名称 | 肿瘤坏死因子相关凋亡诱导配体抗体 |
| 英文别名 | Tumor necrosis factor ligand superfamily member 10; APO2L; TNFSF10; Apo 2 ligand; Apo 2L; CD 253; CD253; CD253 antigen; Protein TRAIL; TL 2; TL2; TNF Related Apoptosis Inducing Ligand; TNF related apoptosis inducing ligand TRAIL; TNFSF 10; TNFSF10 protein; TRAIL PEN; Tumor Necrosis Factor(ligand) Superfamily Member 10; TNF10_HUMAN. |
| 产品应用 | WB=1:500-2000, IHC-P=1:100-500, IHC-F=1:100-500, IF=1:100-500 Not yet tested in other applications. |
| 交叉反应 | Human, Mouse, Rat |
| 抗体来源 | Rabbit |
| 免疫原 | KLH conjugated synthetic peptide derived from human TRAIL |
| 亚型 | IgG |
| 性状 | Liquid |
| 纯化方法 | affinity purified by Protein A |
| 克隆类型 | Polyclonal |
| 理论分子量 | 31 kDa |
| 浓度 | 1mg/ml |
| 储存液 | 0.01M TBS (pH7.4) with 1% BSA, 0.02% Proclin300 and 50% Glycerol. |
| 研究领域 | Cancer > Cell Death > Apoptosis > Receptors > Death receptors & ligands > TRAIL Cancer > Invasion/microenvironment > Apoptosis > Death receptors & ligands > TRAIL Cardiovascular > Atherosclerosis > Apoptosis Cell Biology > Apoptosis > Extracellular Signals > Death Ligands |
| 亚基 | Homotrimer. |
| 亚细胞定位 | Membrane; Single-pass type II membrane protein (Potential). |
| 组织特异性 | Widespread; most predominant in spleen, lung and prostate. |
| 相似性 | Belongs to the tumor necrosis factor family. |
| 功能 | Cytokine that binds to TNFRSF10A/TRAILR1, TNFRSF10B/TRAILR2, TNFRSF10C/TRAILR3, TNFRSF10D/TRAILR4 and possibly also to TNFRSF11B/OPG. Induces apoptosis. Its activity may be modulated by binding to the decoy receptors TNFRSF10C/TRAILR3, TNFRSF10D/TRAILR4 and TNFRSF11B/OPG that cannot induce apoptosis. |
| 保存条件 | Shipped at 4℃. Store at -20℃ for one year. Avoid repeated freeze/thaw cycles. |
| 注意事项 | This product as supplied is intended for research use only, not for use in human, therapeutic or diagnostic applications. |
| 背景资料 | The protein encoded by this gene is a cytokine that belongs to the tumor necrosis factor (TNF) ligand family. This protein preferentially induces apoptosis in transformed and tumor cells, but does not appear to kill normal cells although it is expressed at a significant level in most normal tissues. This protein binds to several members of TNF receptor superfamily including TNFRSF10A/TRAILR1, TNFRSF10B/TRAILR2, TNFRSF10C/TRAILR3, TNFRSF10D/TRAILR4, and possibly also to TNFRSF11B/OPG. The activity of this protein may be modulated by binding to the decoy receptors TNFRSF10C/TRAILR3, TNFRSF10D/TRAILR4, and TNFRSF11B/OPG that cannot induce apoptosis. The binding of this protein to its receptors has been shown to trigger the activation of MAPK8/JNK, caspase 8, and caspase 3.(tumor necrosis factor-related apoptosis-inducing ligand) |
| 应用 | 推荐稀释比例 |
| {WB} | {1:500-2000} |
| {IHC-P} | {1:100-500} |
| {IHC-F} | {1:100-500} |
| {IF} | {1:100-500} |

Lung (Mouse) Lysate at 30 ug
U251 Cell Lysate at 30 ug
Primary: rabbit Anti- TRAIL (bs-1214R) at 1:300 dilution;
Secondary: HRP conjugated Goat-Anti-rabbit IgG(bs-0295G-HRP) at 1:5000 dilution;
Predicted band size: 31 kD
Observed band size: 26 kD
Antigen retrieval: citrate buffer ( 0.01M, pH 6.0 ), Boiling bathing for 15min; Block endogenous peroxidase by 3% Hydrogen peroxide for 30min; Blocking buffer (normal goat serum,C-0005) at 37℃ for 20 min;
Incubation: Anti-TRAIL Polyclonal Antibody, Unconjugated(bs-1214R) 1:200, overnight at 4°C, followed by conjugation to the secondary antibody(SP-0023) and DAB(C-0010) staining

Antigen retrieval: citrate buffer ( 0.01M, pH 6.0 ), Boiling bathing for 15min; Block endogenous peroxidase by 3% Hydrogen peroxide for 30min; Blocking buffer (normal goat serum,C-0005) at 37℃ for 20 min;
Incubation: Anti-TRAIL Polyclonal Antibody, Unconjugated(bs-1214R) 1:200, overnight at 4°C, followed by conjugation to the secondary antibody(SP-0023) and DAB(C-0010) staining
风险提示:丁香通仅作为第三方平台,为商家信息发布提供平台空间。用户咨询产品时请注意保护个人信息及财产安全,合理判断,谨慎选购商品,商家和用户对交易行为负责。对于医疗器械类产品,请先查证核实企业经营资质和医疗器械产品注册证情况。
文献和实验[IF={{ 7.129 }}] {Furui Han. et al. In vivo and in vitro study on hepatotoxicity of Tris-(2, 3-dibromopropyl) isocyanurate exposure via mitochondrial and death receptor pathway. ECOTOX ENVIRON SAFE. 2022 Nov;246:114186} {WB} {Rat, Human}
[IF={{ 6.291 }}] {Haojie Li. et al. Calcium alleviates fluoride-induced kidney damage via FAS/FASL, TNFR/TNF, DR5/TRAIL pathways in rats. Ecotox Environ Safe. 2021 Dec;226:112851} {WB} {Rat}
[IF={{ 4 }}] {Kangqin Yang. et al. Astrocytes Contribute to Motor Neuron Degeneration in ALS via the TRAIL‐DR5 Signaling Pathway. J NEUROCHEM. 2025 Jul;169(7):e70146} {IF} {Mouse}
[IF={{ 3.9 }}] {Tang Yu. et al. Chlorogenic acid attenuates oxidative damage in rat lacrimal gland epithelial cells via PI3K/AKT/FoxO3 signaling: network pharmacology and experimental evidence. SCI REP-UK. 2025 May;15(1):1-15} {WB} {Rat}
[IF={{ 3.53 }}] {Fang C, Zhang J, Qi D, Fan X, Luo J, et al. (2014) Evodiamine Induces G2/M Arrest and Apoptosis via Mitochondrial and Endoplasmic Reticulum Pathways in H446 and H1688 Human Small-Cell Lung Cancer Cells. PLoS ONE 9(12): e115204.} {WB} {="Human"}
= NAL), appears to form upon oxidative cyclization of the nonfluorescent 2:1 lysine-HNE Michael adduct-Schiff base cross-link (Scheme 1). Polyclonal antibody (PAb) to the NAL-HNE fluorophore was raised in rabbit and found to be highly specific
T 2000/3000 进口分装 F0290 TNF 相关凋亡诱导配体 (TRAIL/APO2 Ligand) ELISA 48T/96T 2000/3000 进口分装 F0291 血栓前体蛋白(TpP) ELISA 48T/96T 2000/3000 进口分装 F0300 尿激酶型纤溶酶原激活因子(uPA) ELISA 48T/96T 2000/3000 进口分装 F0301 尿激酶型纤溶酶原激活因子受体(uPA-R) ELISA 48T
T 2000/3000 进口分装 F0290 TNF 相关凋亡诱导配体 (TRAIL/APO2 Ligand) ELISA 48T/96T 2000/3000 进口分装 F0291 血栓前体蛋白(TpP) ELISA 48T/96T 2000/3000 进口分装 F0300 尿激酶型纤溶酶原激活因子(uPA) ELISA 48T/96T 2000/3000 进口分装 F0301 尿激酶型纤溶酶原激活因子受体(uPA-R) ELISA 48T
技术资料暂无技术资料 索取技术资料









